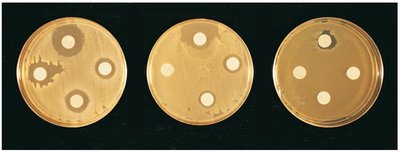
Disk-diffusion method showing zones of inhibition
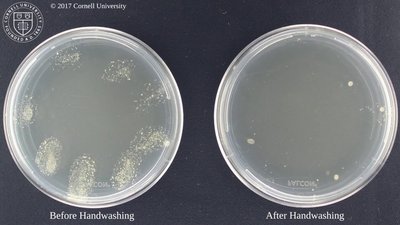
Petri dish comparison before and after handwashing

BackMicrobial Control and Genetics: Mini-Textbook Study Notes
Study Guide - Smart Notes
Tailored notes based on your materials, expanded with key definitions, examples, and context.
The Control of Microbial Growth
Introduction to Microbial Control
Microbial control is essential in medical, laboratory, and industrial settings to prevent contamination and infection. There are three main approaches: physical and chemical methods, chemotherapeutic drugs, and immune system interventions.
Sepsis: Refers to bacterial contamination.
Asepsis: Absence of significant contamination.
Aseptic techniques: Used in surgery and laboratory to prevent microbial contamination.
Key Terms in Microbial Control
Understanding terminology is crucial for distinguishing between methods and outcomes.
Disinfection: Destruction of microbes on inanimate objects; does not achieve sterility.
Antiseptic: Chemical disinfection of living tissues; does not destroy living tissue.
Sterilization: Complete destruction of all forms of microbial life, including endospores and viruses.
Germicide: Chemical agent that kills microbes but not necessarily endospores.
Bacteriostatic: Inhibits microbial growth without killing.
Bactericidal: Kills microorganisms.
Types of Microbial Suppression
Microbial suppression can be achieved through various agents, each with distinct effects on microbial populations.
Bacteriostatic agents: Halt growth but do not kill microbes.
Bactericidal agents: Kill microbes, reducing their numbers.

Microbial Death Curve and Rate of Death
The rate at which microbes die is influenced by several factors, including the number of microbes, temperature, type of microbe, physiological state, and cell environment.
Logarithmic death curve: Microbial death often follows a logarithmic pattern, where a constant percentage of cells die per unit time.
Factors affecting death rate: Number of microbes, temperature, type of microbe, physiological state, and cell environment (e.g., presence of organic matter, pH).

Actions of Microbial Control Agents
Microbial control agents act by altering membrane permeability, damaging proteins and nucleic acids, inhibiting cell wall synthesis, and other mechanisms.
Alteration of membrane permeability: Agents act on lipids and proteins in the plasma membrane.
Damage to proteins and nucleic acids: Denaturation of proteins and breakdown of nucleic acids.
Inhibition of cell wall synthesis: Some antibiotics prevent synthesis of new cell wall.
Physical Methods of Microbial Control
Physical methods include heat, filtration, cold, desiccation, osmotic pressure, and radiation.
Heat: Denatures enzymes.
Thermal death point (TDP): Lowest temperature at which all cells in a liquid culture are killed in 10 minutes.
Thermal death time (TDT): Minimal time for all bacteria in a liquid culture to be killed at a particular temperature.
Decimal reduction time (DRT): Minutes to kill 90% of a specific population of bacteria at a given temperature.

Moist Heat
Moist heat methods include boiling, free-flowing steam, and pressurized steam (autoclaving).
Boiling: Disinfects but does not sterilize.
Autoclaving: Sterilizes at 15 psi and 121°C for 15 minutes, killing all organisms and spores.

Low Heat
Pasteurization: Reduces spoilage organisms and pathogens by heating materials for a short time.
High-temperature short-time (HTST): 72°C for 15 sec
Ultra-high-temperature (UHT): 140°C for 4 sec
Dry Heat
Flaming, incineration, and hot-air sterilization are used for sterilizing materials.

Filtration
Filtration is used for heat-sensitive materials, removing microbes larger than 0.22 μm.
Membrane filters: Remove microbes from solutions.

Cold, Desiccation, and Osmotic Pressure
Low temperature: Bacteriostatic effect (refrigeration, deep-freezing, lyophilization).
Desiccation: Absence of water prevents metabolism.
Osmotic pressure: High concentrations of salts and sugars create a hypertonic environment, causing plasmolysis.

Radiation
Ionizing radiation: X-rays, gamma rays, electron beams; damages DNA by causing lethal mutations.
Nonionizing radiation: Ultraviolet; creates thymine dimers in DNA.
Microwaves: Kill by heat, not especially antimicrobial.

Chemical Methods of Microbial Control
Disk-Diffusion Method
The efficacy of chemical agents is evaluated by soaking filter paper disks in chemicals and placing them on a culture. The zone of inhibition indicates effectiveness.
Phenols and Bisphenols
Phenols: Injure lipids of plasma membranes.
Bisphenols: Contain two phenol groups; disrupt plasma membranes.

Essential Oils
Mixtures extracted from plants; effective due to phenolics and terpenes.

Halogens
Iodine: Impairs protein synthesis and alters membranes.
Chlorine: Oxidizing agent; shuts down cellular enzyme systems.
Alcohols
Denature proteins and dissolve lipids; no effect on endospores and nonenveloped viruses.
Ethanol and isopropanol require water for effectiveness.

Heavy Metals
Ag, Hg, Cu, Zn: Denature proteins, act on -SH groups.

Surface-Active Agents
Soap: Degerming, emulsification.
Quaternary ammonium compounds (Quats): Denature proteins and disrupt membranes.
Chemical Food Preservatives
Inhibit metabolism in microbes; humans can metabolize.
Sorbic acid, benzoic acid, calcium propionate: Control molds and bacteria in foods and cosmetics.
Sodium nitrate: Prevents endospore germination.
Nisin and natamycin: Antibiotics prevent spoilage of cheese.

Aldehydes
Inactivate proteins by cross-linking with functional groups; used for preserving specimens and medical equipment.
Formaldehyde and glutaraldehyde are common examples.

Chemical Sterilization
Gaseous sterilants cause alkylation, cross-linking nucleic acids and proteins; used for heat-sensitive materials (e.g., ethylene oxide).
Summary of Microbial Control
Chemical and physical methods are non-specific and affect any protein, lipid, or membrane.
Antibiotics (chemotherapy) are more organism-specific.
Microbial Genetics
Central Dogma and Terminology
Microbial genetics studies the structure, function, and regulation of genes. The central dogma describes the flow of genetic information: DNA → RNA → Protein.
Genetics: Study of genes.
Chromosomes: Structures containing DNA.
Genes: Segments of DNA encoding functional products.
Genome: All genetic information in a cell.
Genotype: Genetic makeup of an organism.
Phenotype: Expression of genes.

Structure and Function of Genetic Material
Bacteria have a single circular chromosome.
DNA forms a double helix, with antiparallel strands held together by hydrogen bonds (A-T, C-G).
DNA Replication
DNA replication is the process by which DNA is copied before cell division.
Each strand serves as a template for the other.
Replication is semi-conservative, producing two complete double strands.
Key enzymes: Topoisomerase, gyrase, helicase, DNA polymerase, primase, DNA ligase.
Leading strand is synthesized continuously; lagging strand is synthesized discontinuously, creating Okazaki fragments.
Adding a Nucleotide to DNA
Nucleoside triphosphate bonds to sugar, losing two phosphates; hydrolysis provides energy for the reaction.
Bacterial Replication
Cell elongates and DNA is replicated.
Cell wall and plasma membrane constrict, forming a cross-wall and separating two DNA copies.
RNA and Transcription
Ribosomal RNA (rRNA): Integral part of ribosomes.
Transfer RNA (tRNA): Transports amino acids during protein synthesis.
Messenger RNA (mRNA): Carries coded information from DNA to ribosomes.
Transcription in Prokaryotes
mRNA strand is made from DNA template.
RNA polymerase binds to promoter sequence on DNA.
New nucleotides added in 5’→3’ direction.
Transcription ends at terminator sequence.
Translation
mRNA is translated into protein.
Codons are groups of three mRNA nucleotides coding for amino acids.
Translation starts at start codon (AUG) and ends at nonsense codons (UAA, UAG, UGA).
tRNA molecules transport amino acids to ribosome and have anticodons that base-pair with codons.
Amino acids are joined by peptide bonds.
Regulation of Bacterial Gene Expression
Gene Expression and Regulation Terms
Gene expression: Production of the molecule coded by a gene.
Constitutive genes: Expressed at a fixed rate.
Repressible genes: On by default, can be turned off.
Inducible genes: Off by default, can be turned on.
Repression: Inhibits gene expression, mediated by repressors.
Induction: Turns on gene expression, initiated by inducers.
Operons
Operon: Set of operator and promoter sites and the genes they control.
Promoter: DNA segment where RNA polymerase initiates transcription.
Operator: DNA segment controlling transcription.
The lac Operon (Inducible Operon)
Regulated by the product of the regulatory gene (I).
Genes arranged downstream as lacY, lacA, lacZ.
Repressor protein binds operator, preventing transcription when inactive.
Allolactose (inducer) inactivates repressor, allowing transcription.
The trp Operon (Repressible Operon)
Regulated by the product of the regulatory gene (I).
Repressor is inactive, allowing transcription and translation for tryptophan synthesis.
Tryptophan (corepressor) activates repressor, preventing transcription.
Catabolite Repression
Bacteria preferentially use glucose over lactose.
When glucose is depleted, cAMP increases, activating CAP and stimulating lac operon transcription.
High glucose inhibits lac operon expression (catabolite repression).
Mutation
Types of Mutations
Mutation: Stable, inherited change in DNA sequence.
Mutagen: Agent causing mutations (induced mutations).
Spontaneous mutations: Occur without mutagen.
Base substitution (point mutation): Change in a single nucleotide.
Missense mutation: Change in amino acid sequence.
Silent mutation: No change in amino acid sequence.
Nonsense mutation: Premature stop codon.
Frameshift mutation: Insertions or deletions shift reading frame.
Mutagens and DNA Repair
Mutagens include chemicals and radiation.
Ionizing radiation (X-rays, gamma rays) oxidizes nucleotides and breaks DNA backbone.
UV radiation causes thymine dimers; photolyases and nucleotide excision repair fix damage.

Genetic Transfer and Recombination
Gene Transfer in Bacteria
Vertical gene transfer: Occurs during reproduction between generations.
Horizontal gene transfer: Transfer of genes between cells of the same generation.
Methods of Horizontal Gene Transfer
Transformation: Uptake of naked DNA by competent cells.
Conjugation: Cell-to-cell contact via pili; requires conjugative plasmid (F factor).
Transduction: DNA transfer via bacteriophage (virus infecting bacteria); includes generalized and specialized transduction.
Recombination
Combining genes from two different cells produces a recombinant cell.
Summary Table: Physical and Chemical Methods of Microbial Control
Method | Mechanism | Application |
|---|---|---|
Heat (Moist/Dry) | Denatures proteins | Sterilization, disinfection |
Filtration | Removes microbes | Heat-sensitive solutions |
Cold | Bacteriostatic | Food preservation |
Desiccation | Prevents metabolism | Preservation |
Osmotic Pressure | Plasmolysis | Food preservation |
Radiation | Damages DNA | Sterilization |
Phenols/Bisphenols | Disrupt membranes | Disinfectants |
Halogens | Oxidize proteins | Disinfectants, antiseptics |
Alcohols | Denature proteins | Antiseptics |
Heavy Metals | Denature proteins | Antimicrobials |
Surface-Active Agents | Emulsification | Degerming |
Food Preservatives | Inhibit metabolism | Food preservation |
Aldehydes | Cross-link proteins | Preservation, sterilization |
Chemical Sterilization | Alkylation | Sterilization |
Summary Table: Types of Mutations
Type | Description | Effect |
|---|---|---|
Missense | Change in amino acid | Altered protein function |
Silent | No change in amino acid | No effect |
Nonsense | Premature stop codon | Truncated protein |
Frameshift | Insertion/deletion | Altered reading frame |
Summary Table: Horizontal Gene Transfer Methods
Method | Mechanism | Key Features |
|---|---|---|
Transformation | Uptake of naked DNA | Requires competent cells |
Conjugation | Cell-to-cell contact | Requires F factor, sex pilus |
Transduction | Virus-mediated transfer | Bacteriophage, lytic/lysogenic cycles |